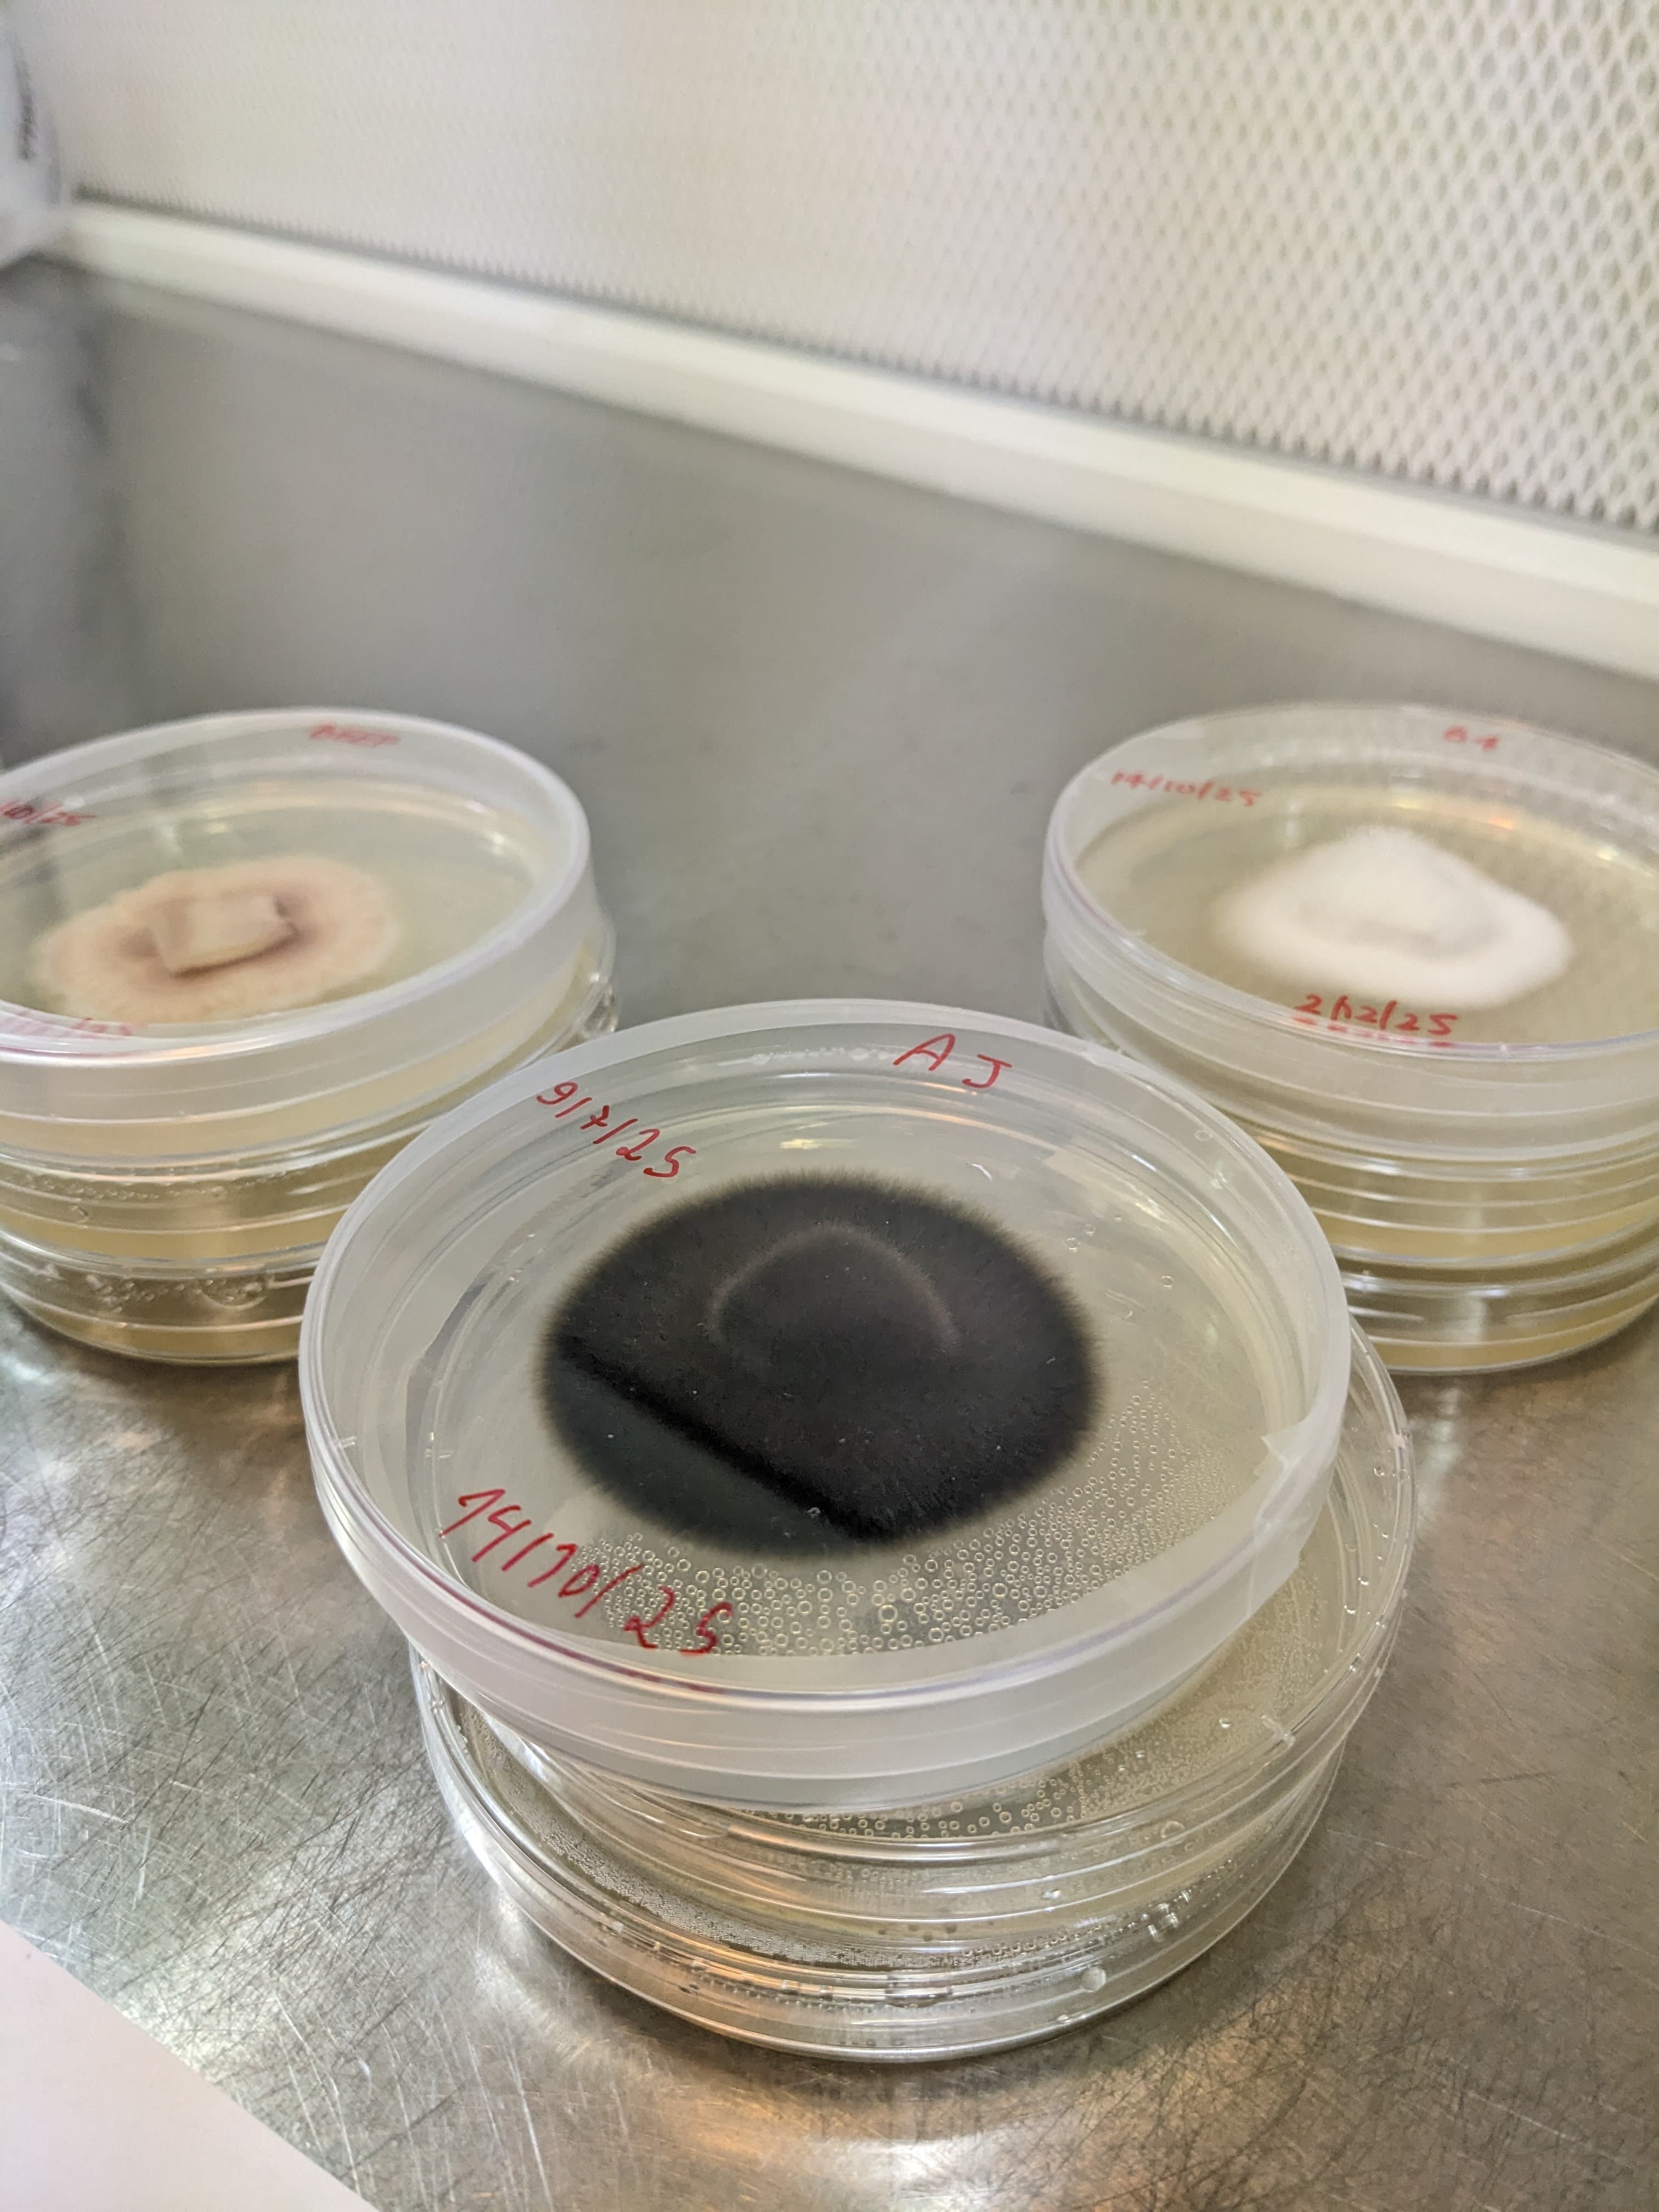
Fungal cultures in petri dishes — eDNA laboratory work

Research
Doctoral Research
Ectomycorrhizal Fungal Community Dynamics in Temperate Broadleaf Forests Under Nitrogen Deposition Stress

Russula nitida
Key indicator species used as sentinels of nitrogen tolerance across the study gradient.
The forests of the British Isles exist in quiet chemical crisis. Decades of atmospheric nitrogen deposition — the invisible byproduct of agriculture and industry — have fundamentally altered the soil chemistry upon which ancient ectomycorrhizal partnerships depend. My doctoral research investigates how these shifts in nitrogen availability reshape the community structure of ectomycorrhizal fungi (EMF) associated with mature oak and beech stands across study sites in England.
Using a combination of environmental DNA metabarcoding, soil chemical profiling, and root-tip morphotyping, I am building the first longitudinal dataset of EMF diversity across a nitrogen gradient. The central hypothesis is that elevated nitrogen enrichment selects for a narrower guild of nitrophilous EMF species, suppressing the rare and specialist taxa that underpin the resilience of mature forest ecosystems.
This matters because ectomycorrhizal fungi are not merely decomposers — they are the primary conduit for phosphorus and water delivery to the root systems of the dominant trees in our temperate forests. A less diverse fungal community is a more fragile one. By identifying the threshold nitrogen loads at which diversity collapses, this research aims to provide the first evidence-based thresholds for conservation management in UK National Landscapes.
Methodology
How the Research is Done
Hover over each tile to reveal the technical methods behind the fieldwork.

Long-Term Decomposition Experiments

Microbial Community Profiling

Fourier-Transform Infrared Spectroscopy

DNA Metabarcoding

Fungal Cultures in vitro
Soil Chemical Analysis
Looking Ahead
Future Directions
The immediate goals of my research extend beyond the thesis. Each finding opens new questions — about conservation policy, ecological restoration, and the industrial potential of fungal biology.